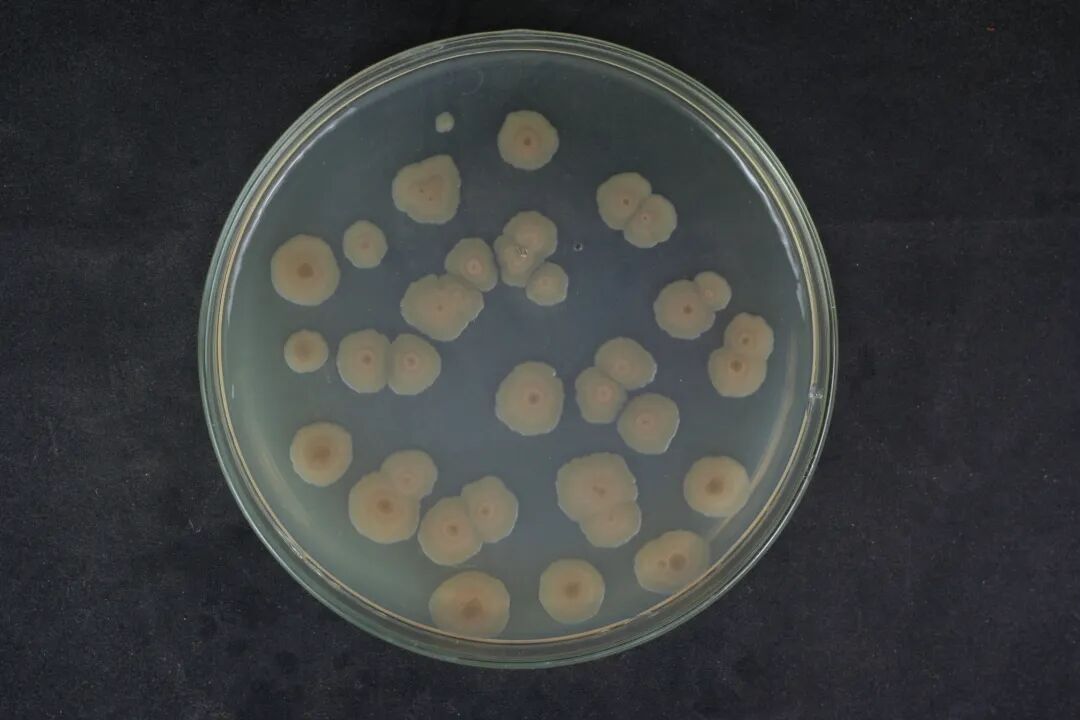

|
$ c/ c+ w o/ w 
* v. e% j, L1 N* h' ` 绿色农业 ]6 P% l4 t9 e3 ]$ \; g; ?0 G
Part 1 - 海水健康养殖微生态产品  # M0 ?7 I& C/ Y& |. C6 A9 l A # M0 ?7 I& C/ Y& |. C6 A9 l A
图片来源于网络
" _( L& ~, t& Z3 u 概述
" g- @, P- k4 @9 j7 m3 w 目前市场上没有专门海洋源菌种的微生态制剂,多为陆源菌种、畜禽养殖用微生态产品。本项目针对对虾、蟹类及海参养殖中抗生素滥用、市售微生态制剂菌株有效性低、发酵水平低下、制剂水平落后导致菌株活性和耐受性低、产品质量不稳定等问题,通过分析由大洋、北极、近海、养殖场以及养殖动物肠道等不同环境采集的样品,筛选具有自主知识产权的专门针对海水健康养殖的益生菌菌种,同时通过对优选菌种复配和辅料添加,获得了真正海洋来源的海洋微生态制剂。
& z% m" v, w! s1 J3 O; f# s1 B1 A 本项目开展具有自主知识产权的特殊功能微生物菌种的工业化发酵工艺、发酵产物的后处理与产品化工艺以及应用技术的研究;获得了海洋益生菌发酵与产品加工工艺,开发的海水养殖微生态制剂具有单位活菌量高、对环境适应能力强、对养殖动物的多种疾病针对性较强、样品保藏期长等特点。并通过安全试验和有效试验,为产品的工业化生产与应用提供成熟的技术。 . s. ?# K" c/ z& ^- Y1 |
为实现海洋微生态制剂的产业化,本项目开展了大规模现场应用与市场推广。通过与企业合作,分别于福建省、江苏省、海南省、广西省共设立14个试验点,总试验面积超2000亩。确定复合微生态制剂在现场应用中改善水质、稳定藻类、促进对虾摄食、降低水体弧菌含量、提高抗病力等功效,通过应用本项目研发成果,示范养殖场均取得了良好经济效益。
1 ^* Q3 P- H v$ k5 Z6 \* n" G+ ^* X Part 2 - 海洋脱氮菌在水产养殖中的应用  3 }' v5 Q! E" U# F6 x; M
3 }' v5 Q! E" U# F6 x; M 图片来源于网络 ; w0 y& e, e2 @* Q
概述 0 u% E. U& Q: u/ n- c \) m% ]
随着现代商业化养殖模式的集约化管理与高密度养殖,过量的饵料被投放到养殖水体,导致养殖环境急剧恶化,氨氮、亚硝酸盐等大量累积,对养殖动物产生毒害作用甚至引起养殖动物的死亡,最终造成巨大的经济损失。 - [. L8 D4 k+ C8 m; y
目前市面上处理氨氮和亚硝酸盐的相关产品,主要包括两类,一类以强氧化剂为主,如过硫酸氢盐,亚氯酸钠,通过氧化作用,直接把有机质氧化;或者使用硫脲等阻断硝化作用。这类产品优点是见效快,使用过后4-6小时就有明显效果。缺点是刺激性大,容易导致养殖动物死亡或者降低活力,维持时间不长,使用过后第二天就开始反弹,会破坏水质稳定性,影响底部生物菌群的生长,也会对藻类有一定杀伤力。另一类为微生物制剂,主要是芽孢杆菌等,这类产品的优点是对养殖动物安全、没有二次污染、维持时间较长等,然而目前市面上针对氨氮、亚硝酸盐的产品非常少,并且仅有的产品见效较慢,针对性很差、效果也很不稳定。因此,开发高效的脱氮菌产品,应用于水产养殖环境氨氮、亚硝酸盐的去除势在必行。 ( h% A+ J& ?4 N5 Y* B3 B
本项目优势:1.海洋脱氮菌生长和脱氮的盐度范围广、温度范围广,能适应于不同盐度的养殖环境,能适应于不同的养殖季节,能去除不同形式的含氮污染物,没有生物安全性风险。2.海洋脱氮菌的生长及脱氮不受氧气限制,能适应于不同溶解氧水平的养殖环境,在高位池或者土池等均具有应用前景。
1 S" S3 v. W3 W8 x 目前水产养殖投入品整体产值规模在200亿元左右,处理氨氮、亚硝酸盐的产品产值为15亿元左右,其中以强氧化剂为主的产品,约占80%以上的市场份额,微生物制剂类产品不到20%,以硝化细菌和反硝化细菌等为原料的产品很少,市场需求巨大,基于现有相关产品优劣势,综合分析,如能生产专门的脱氮产品,所能带来的产值增长潜力巨大。
, n& ~1 O, m7 N L+ B- P Part 3 - 海洋养殖尾水处理技术  # [; N# v5 ]3 G
# [; N# v5 ]3 G 图片来源于网络 . J. k9 P1 J% P; k. O
概述
R. |. a: T- n- K) } 海水养殖过程中会产生大量的养殖尾水,主要含高浓度的氮、磷等有机污染物,直接排放会导致海水富营养化,对海洋生态环境造成巨大危害。
" M+ n6 |6 b+ u8 j2 p9 }& T 以海洋反硝化微生物为主体,构建微生物菌群,结合固定化技术建立生物反应池,可以高效的去除养殖尾水中的氮、磷等有机污染物,使养殖尾水达到一级海水养殖废水排放标准。 3 [9 M6 W0 J+ R" X4 d& b4 @: z7 V
海洋反硝化微生物耐盐,环境适应性强,可在有氧情况下快速还原硝酸盐,环境友好,无二次污染,在海水养殖尾水处理上具有良好的应用前景。
) y( f( ?0 u, j: E Part 4 - 防治植物致病真菌产品 6 `/ l* @, F% S) H9 p# s 6 `/ l* @, F% S) H9 p# s
图片来源于网络
* s) e) D. |0 U3 v7 Q6 A" ^/ S( p 概述
: s+ u! n% K! |- [ 芽孢杆菌Pc3来源于海洋环境,具有抑菌谱广、环境友好等特点,可以抑制绿色木霉、胶孢炭疽菌、核盘菌、尖孢镰刀菌、长柄链格孢、立枯丝核菌和宛氏拟青霉。 ) ]: [& H0 {# M+ p7 ]
芽孢杆菌Pc3为安全绿色的生物农药,制备工艺简单,制造成本低,可有效减少各种病害发生,降低和消除各种药残隐患,提升农产品品质和安全,增加商品价值,从而提高生产经营效益,因而其作为农用海洋生物制品市场前景广阔,产品本身的生产和销售将产生良好的经济效益。生物农药与化学农药复配技术,可以达到减施增效的作用。 3 E! x% Q3 _* y+ N; F* F% F$ O
Part 5 - 抗乌龙茶真菌病害用生防菌剂  2 R0 U( k- F4 ]5 x/ b, q: L! N
2 R0 U( k- F4 ]5 x/ b, q: L! N 图片来源于网络 6 K! c- e1 `' H& y) c, X
概述
0 e: m& D: k0 G! l 目前国际上微生物源农药主要包括两大类,一类是活体微生物制剂,即活体病毒、细菌、真菌、放线菌等,一类是细菌、真菌、放线菌等微生物产生的次生代谢产物及农用抗生素。
6 ~/ O/ w! z- q! k- T 本产品为针对乌龙茶真菌病害专用的深海微生物生防菌剂,具有完全的自主知识产权,技术成熟,小样在田间测试效价与化学农药效价接近。目前针对茶叶的生防菌剂尚未见市场类似产品。
" M E: V" B. r- e! S) l& A 本产品由于为活菌制剂,其环境安全性评估还要进行相应工作。 ; d' D) K! f" \6 r4 @
Part 6 - 农产品消毒用杀菌剂  ( ~5 O# }8 L5 T8 ~0 g1 p4 y ( ~5 O# }8 L5 T8 ~0 g1 p4 y
图片来源于网络
7 l' [9 x7 S. \8 J: g+ F. I# F 概述 % f+ y0 V! [( K/ i9 ^5 a
本成果直接从海洋极端环境中筛选抗菌遗传特性稳定、且抗菌物质为蛋白(肽)类的功能菌,应用微生物发酵技术和蛋白(肽)盐析协同色谱分离纯化工艺,生产海洋微生物杀菌剂,用于水产养殖过程中常见细菌性病害防治,避免药残,提升水产品安全水平,因此有较好的市场应用前景和较大的市场需求。
3 Z# O) }( F6 \: u9 x 本产品还可有效杀灭食品主要污染菌包括金黄色葡萄球菌、大肠杆菌及杂菌等,可用于农产品特别是冷冻水产品、食品、果蔬的消毒、保藏。
9 _! P/ {, S. p# Q/ {, ~: y Part 7 - 植物生长调节剂  $ I1 k5 u7 q% Z) e$ ?2 x: d, G0 d
$ I1 k5 u7 q% Z) e$ ?2 x: d, G0 d 图片来源于网络 ) S$ ?. i7 `2 Q( m0 U3 X/ f: M
概述
: {0 R2 G$ h$ f3 ?& N 利用低值海藻,设计采用“温和”浸提工艺,最大限度保留海藻内源植物激素等活性物质,研发海藻源植物生长调节剂,调节农作物生长(促生长、防病、抗逆等),提升农产品品质与农产品价值,减少肥料使用量,保护环境,促进现代农业的可持续性发展。
* m7 z: J+ G# f# U1 T9 s1 r 目前市场上,海藻源植物生长调节剂相关产品还比较少。
% ~5 v4 B8 M" h0 s- d; V& a Part 8 - 海藻源菌肥  # d, J2 f$ P6 R; `
# d, J2 f$ P6 R; ` 图片来源于网络 . C# q* t/ |4 r
概述 ' _9 r/ r4 b. N5 J! P. ^ _( C+ y
利用低值海藻以及海洋益生菌,设计采用固体发酵工艺,最大限度保留海藻有机营养物质以及获得大量有益微生物。制备海藻源固体菌肥,可以促进植物或农作物生长,增强植物抗病力,防治病害,用于农作物种植领域。 9 I* N% B- g+ A( \- P' c- {
与同类产品相比,原料来源成本低,产生的菌肥可以提供植物很好的有机质营养,以及提高抗病害能力,降低化肥及化学农药的使用量,减少环境污染,符合国家农药化肥“双减”政策。 9 @& |0 u; ^. B( G( k' }
Part 9 - 对虾生态养殖尾水处理系统  7 }* ~1 n% ?5 Y) _- d: J# {
7 }* ~1 n% ?5 Y) _- d: J# { 图片来源于网络
# X3 {+ X. ~, k2 O/ a# d 概述
. }4 X. ], s, f0 P 针对对虾养殖尾水排放BOD等超标,造成养殖海域富营养化现状,采用生物、物理等手段,利用海洋微生物、海洋生物材料开发对虾养殖尾水处理系统,有效降低尾水中氨氮、亚硝酸盐等造成富营养化的有害物质,达到国家排放标准,促进对虾生态养殖健康发展。技术适用于对虾室内高位池养殖以及室外池塘养殖。
0 g; S9 X8 X3 N, K( Z$ c1 H2 K0 @ contact
/ D3 Q: F% S& P4 ~% J) I3 V 联系 8 t% k" o2 C& N3 g# @* Y
我们
+ W: a9 }$ T& N# A5 Z6 u* A" B8 ] 合作方式:面议
5 J9 H' o6 F2 ^* f 可添加下方老师企业微信咨询 ( X) F5 b- R5 f+ ?+ G: U3 j
段老师|18950095573        0 B0 |7 \- Q/ T) s
0 B0 |7 \- Q/ T) s 点击“往期回顾”查看推荐文章 + d7 ~0 [# ]! N* ?* M$ A% [. B; A
 fill=%23FFFFFF%3E%3Crect x=249 y=126 width=1 height=1%3E%3C/rect%3E%3C/g%3E%3C/g%3E%3C/svg%3E)
# y) I9 T# e; U, j6 \& V3 r" h9 h1 ~! O" F
/ x$ e8 f/ C2 E/ [
| 

